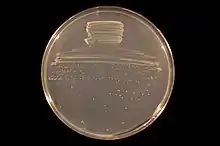

Bradyrhizobium diazoefficiens
Bradyrhizobium diazoefficiens is a species of bacteria from the genus of Bradyrhizobium.[3][4]
| Bradyrhizobium diazoefficiens | |
|---|---|
![]() | |
| Bradyrhizobium diazoefficiens strain USDA 110 on an agar plate | |
| Scientific classification | |
| Domain: | Bacteria |
| Phylum: | Pseudomonadota |
| Class: | Alphaproteobacteria |
| Order: | Hyphomicrobiales |
| Family: | Nitrobacteraceae |
| Genus: | Bradyrhizobium |
| Species: | B. diazoefficiens |
| Binomial name | |
| Bradyrhizobium diazoefficiens Delamuta et al. 2013[1] | |
| Type strain | |
| 3I1B110, ACCC 15034, BCRC 13528, CCRC 13528, CCT 4249, CNPSo 46, IAM 13628, IFO 14792, JCM 10833, NBRC 14792, NIFTAL 102, NRRL B-4361, NRRL B-4450, R-12974, SEMIA 5032, TAL 102, TISTR 339 , USDA 110[2] | |
References
- LPSN lpsn.dsmz.de
- Straininfo of Bradyrhizobium diazoefficiens
- Delamuta, J. R.; Ribeiro, R. A.; Ormeño-Orrillo, E; Melo, I. S.; Martínez-Romero, E; Hungria, M (2013). "Polyphasic evidence supporting the reclassification of Bradyrhizobium japonicum group Ia strains as Bradyrhizobium diazoefficiens sp. nov". International Journal of Systematic and Evolutionary Microbiology. 63 (Pt 9): 3342–51. doi:10.1099/ijs.0.049130-0. PMID 23504968.
- UniProt
External links
This article is issued from Wikipedia. The text is licensed under Creative Commons - Attribution - Sharealike. Additional terms may apply for the media files.